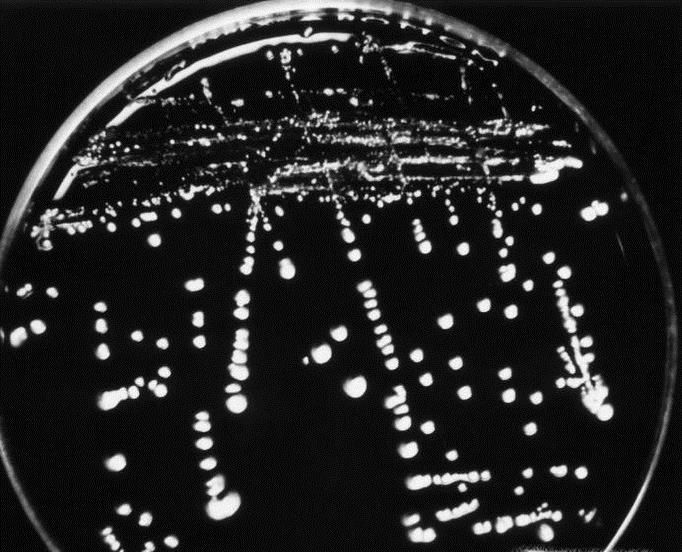

-

CAD中如何快速填充图案
CAD制图中有时候需要填充图案来表征不同物体或者不同特征,下面我就来谈谈CAD中如何快速填充图案。 01、首先,打开一个CAD文档来演示,如图所示,需要往方框内填充图案。点击菜单栏“绘图”,然后下拉...
2023-02-12阅读量:104
-

百分数和小数、分数的互化
在小学的课程中,百分数和小数,分数的互化是一个比较难的知识点,下面我们来看一看如何实现百分数和小数,分数的互化。 01、百分数和小数的互化:百分数和小数的互化比较简单,百分数化为小数,只需要去掉...
2023-02-12阅读量:168
-

cad怎么画多重引线
CAD画图中经常要画多重引线,加入文字来对图形进行注释和解说,下面我就来讲讲cad怎么画多重引线。 01、首先,打开一个CAD图形进行演示,我们在其中画多重引线。 02、点击菜单栏“标注”,然后下...
2023-02-12阅读量:110
-

在cad当中怎样改变线条
CAD在工程制图中有广泛的应用,那么在cad当中怎样改变线条呢?下面我来演示一下。 01、首先,我们打开CAD软件,并画一条直线做演示用。 02、我们先来演示一下改变线条颜色,鼠标点击...
2023-02-12阅读量:124
-

逻辑思维训练方法,提高逻辑思维能力
在互联网信息冲击的时代,片段消息或者信息铺天盖地,人们的逻辑变得越来越混乱。而一个好的逻辑思维能够使做事情事半功倍,帮助我们快速理清头绪。下面小编就讲讲一些思维训练方法来提高我们的逻辑思维能力。 ...
2023-02-12阅读量:104
-

中国知网论文查重入口
很多专业在本科毕业或者硕士研究生或者博士研究生毕业时,都要写一篇论文。学校对学生写的论文都有要求,至少不能抄袭,今天就来教大家如何查询自己的论文重复率。 01、首先打开浏览器,各种浏览器都可以,...
2023-02-12阅读量:147
-

提升学历的最好方法
我们结束学校生活步入社会参加工作之后,才意识到学历对我们来说多重要。因此很多人都想如何提升自己的学历,实现自我价值的提升。 01、参加自考:参加自考进入一所理想的大学,需要付出很多的努力...
2023-02-12阅读量:138
-

教育应有的基本含义
教育这个词语,对于老师们来说是很容易理解的,可是对于很多家长来说,则会有很多不同的理解。那么,教育的基本含义是什么呢?怎样去理解教育一词的含义呢? 01、古人云“师者,传道授业解惑者也”...
2023-02-12阅读量:132
-

wps文字怎么变成图片格式
有时候,我们可能需要把文档变成图片格式,方便储存和查看。下面我就来演示一下wps文字怎么变成图片格式 01、首先,我们打开一篇WPS文档来演示。 02、点击左上角“WPS文字”旁边的下拉菜单倒三角...
2023-02-12阅读量:118
-
细菌菌落和真菌菌落的区别是什么?
在初中生物中,我们要了解什么是真菌和细菌,所以在章节学习中我们学习到了菌落,菌落就是细菌或真菌繁殖后形成肉眼可见的集合体,下面小编就给大家讲讲真菌和细菌菌落的区别是什么。 01、首先通过肉眼直接...
2023-02-12阅读量:108
热门文章
1.绝地求生大逃杀怎么开瞄准镜
- 1

- 绝地求生大逃杀怎么开瞄准镜
- 2022-12-14
- 1
2.gta5线上模式赚钱攻略
- 2

- gta5线上模式赚钱攻略
- 2022-12-14
- 2
3.怎样用网通去电信区玩LOL?
- 3

- 怎样用网通去电信区玩LOL?
- 2022-12-14
- 3
4.dnf辅助装备怎么带
- 4

- dnf辅助装备怎么带
- 2022-12-14
- 4
5.造梦西游5宠物(灵宠)怎么获得。
- 5

- 造梦西游5宠物(灵宠)怎么获得。
- 2022-12-14
- 5
6.红警3秘籍大全
- 6

- 红警3秘籍大全
- 2022-12-14
- 6
7.嗨氏电脑按键设置教程
- 7

- 嗨氏电脑按键设置教程
- 2022-12-14
- 7
8.暗黑血统2图文攻略
- 8

- 暗黑血统2图文攻略
- 2022-12-14
- 8
9.dnf耳环任务格拉古尔在哪?dnf90耳环任务流程?
- 9

- dnf耳环任务格拉古尔在哪?dnf90耳环任务流程?
- 2022-12-14
- 9
10.怎么在Word文档的非第一页,设定页码为“1”
- 10

- 怎么在Word文档的非第一页,设定页码为“1”
- 2022-12-14
- 10
猜您喜欢

Excel表格里垂直滚动条怎么调长?
2022-12-14

Word2013中打印快捷键一览表设置
2022-12-14

怎样修改iTunes备份目录路径释放C盘空间
2022-12-14

怎么设置一台电脑两台显示器两个屏幕
2022-12-14

怎样用光盘重装联想电脑系统
2022-12-14

如何解决winxp开机后不显示桌面
2022-12-14

新手如何利用模板做出好看的PPT?
2022-12-14

电脑开机提示press any key to restart怎么办
2022-12-14

Office2016是否激活,Office2016是否永久激活
2022-12-14

如何设置2345影视大全离线缓存路径?
2022-12-14
